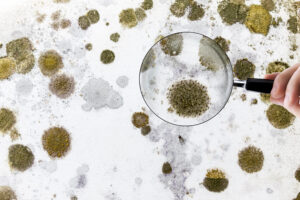
mold

It is important that you address the issue of mold growth in crawl spaces. If not, this mold may move easily from the crawl area up to the living space and may cause a serious problem. For homeowners, it is important that the check and inspect the crawl spaces regularly. Make sure it is dry because if moisture is excessive and it has poor ventilation, molds will grow and flourish. You will instantly know if your crawl spaces have mold because the air you breathe can be stuffy and has a nasty smell.
You can also check your beams for possible mold grown as well as your insulation. The best way to prevent molds from thriving in crawl spaces is through the regular airing of your home. If you think that this is not an option for you, treat the crawlspace regularly with anti-fungus solutions or you can try using a dryer to keep the air dry. Do not wait for mold to flourish on your crawlspace, treat it right away.
Solutions
Molds thrive in moist places; so, you can expect to see molds in any areas where condensation is high. Below are the tips you can follow to minimize the hazards caused by molds in your crawlspaces.
- Remove any excess water in your crawlspaces
Check out the structural parts of the area. See if there are any loose wires or leakage. Particularly check the areas where water can accumulate. If you see any water accumulating, remove the water and dry out the area.
- Clean the crawlspaces up
Once the area is already free from excess water, clean it up right away. Remove any items especially if it is used as your storage room. Make sure that the place is free of any clutter.
- Eliminate the mold
If the area is already free from any items and garbage, you will be able to clearly see any sign of mold. When you see one, the best solution is to remove completely. An oxygen-based cleaner is the best option for removing mold. Apply the cleaner in all spaces to make sure that no mold is left untouched. Then rinse it and let it dry.
- Protect the crawlspaces
Once your crawlspace is already clean and mold-free, you can begin to protect it against moisture by applying a moisture barrier and termite-control solution in the entire area including the foundation.


